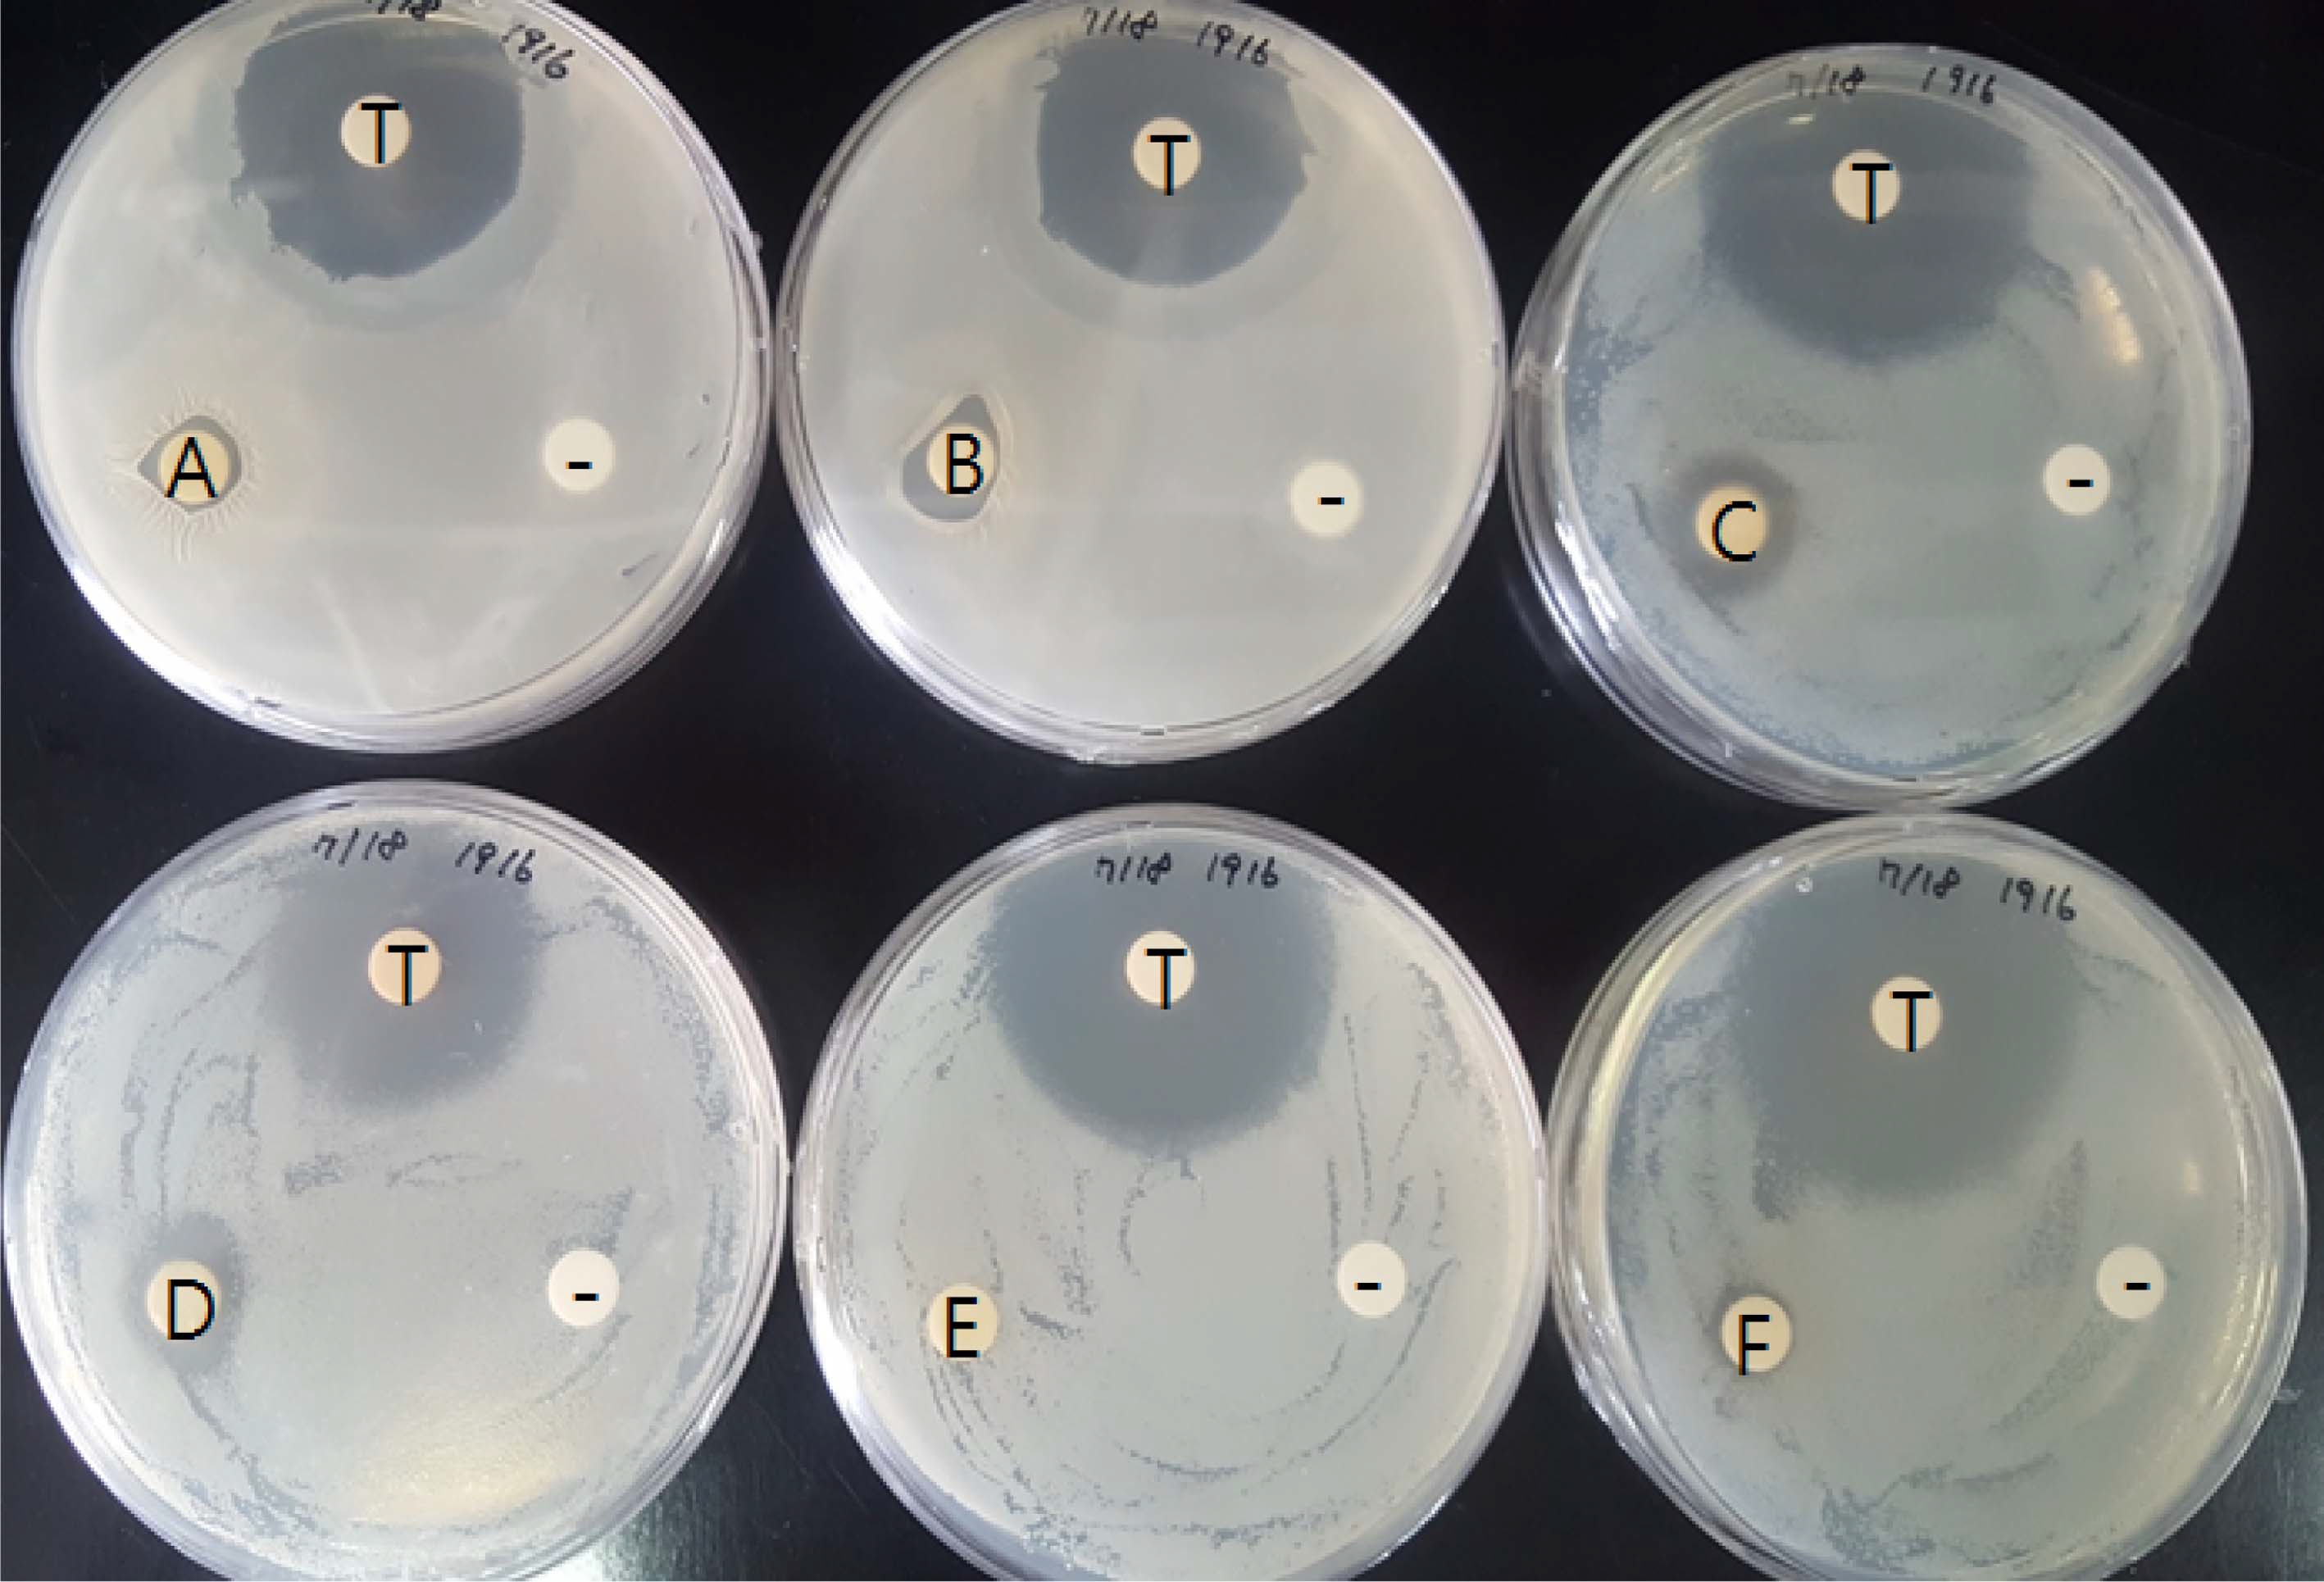
Fig. 5

전나무 부산물 추출물의 항산화 및 항박테리아 활성
© The Korean Society of Medicinal Crop Science. All rights reserved.
This is an Open-Access article distributed under the terms of the Creative Commons Attribution Non-Commercial License ( http://creativecommons.org/licenses/by-nc/3.0 ) which permits unrestricted non-commercial use, distribution, and reproduction in any medium, provided the original work is properly cited.
Abstract
The extract of Abies holophylla is used as an ingredient in cosmetics. This study assessed the antioxidant and antibacterial activities of the material remaining after the extract is used.
The 1,1-diphenyl-2-picrylhydrazyl (DPPH) and 2,2-azinobis (3-ethyl benzothiazoline)-6-sulfonic acid (ABTS) radical scavenging abilities were assessed to determined the free radical scavenging activity. The total phenol and flavonoid contents were determined to measure the antioxidant activity. The DPPH and ABTS radical scavenging activities of the resudual extract were higher (95.61 - 99.42% and 74.26 - 77.98% in water extract respectively) than those of the positive control. In 50% EtOH extract, the total phenol content was 389.84 ㎎·GAE/㎖, and the total flavonoid was 0.15 ㎎·QE/㎖. The minimum inhibition concentration degree for antibacterial activity against Staphylococcus aureus was < 8 to < 125 μg/ml compared to that of the positive control in all extracts. The clear zone against S. aureus was found to be 12.2 ± 3.8 ㎜.
The A. holophylla byproducts were found to have antioxidant and antibacterial activities. Therefore, the materials remaining after the A. holophylla extract is used in cosmetics has potential functional uses.
Keywords:
Abies holophylla, Staphylococcus aureus, Antioxidant Activity, Antibacterial Activity, Funtional Material서 언
전나무 속 (Abies)은 지리적으로 전세계의 북반구에 약 48 여 종이 분포하고 있으며, 우리나라에 자생하고 있는 종류는 전나무 (A. holophylla Maxim), 분비나무 (A. nephrolepis Maxim), 구상나무 (A. koreana Wilson)가 자생하는 것으로 알려져 있다 (Lee, 1987).
구상나무는 우리나라 한라산, 덕유산, 지리산 등에 자생하는 특산종으로, 구과 색이 푸른색을 띄는 푸른구상 (A. koreana for. chlorocarpa T. Lee), 검은색을 띄는 것은 검은구상 (A. koreana for. nigrocarpa Hatus.), 붉은색을 띄는 것은 붉은구 상 (A. koreana for. rubrocarpa T. Lee) 3 종류로 분류된다 (Lee et al., 2006).
전나무 (A. holophylla MAX.)는 음지식물로서 초기 생장이 느리고 천이의 극상을 이루는 생태적 특성을 지니고 있으며, 재질이 우수한 유전자원 선발과 유전다양성 유지를 위해 유전 자원보존전략 및 육종계획에 대한 선행이 연구되어져 왔다 (National Research Council, 1991). 전나무 종류 중 Abies koreana 종은 제주도를 포함한 우리나라 남쪽지역에 해발 1,000 - 1,900 m 되는 산지에서 자라고 있다 (Farjon and Rushforth, 1989). 전나무는 나무자체 수피에 흰빛을 띄어서 백송으로도 불리며, 소나무와 잣나무 곁에서 자라기 때문에 측 백이라는 이름으로도 불려져 왔다 (Lee et al., 2006).
우리나라의 풍부한 산림자원 중 활엽수를 이용한 기능성 물 질에 대한 관심은 매우 활발하게 연구되어져왔으나 (Bolormaa et al., 2011), 침엽수를 이용한 천연물 대사에 관한 연구는 매 우 제한적이었다. 우리나라 대표적인 침엽수종인 소나무, 잣나 무 잎 등에 대한 추출성분 연구도 아직 많이 미흡한 실정이다.
최근 들어, 수목의 목재나 잎으로부터 생리활성 효과가 높 은 기능성 물질 활용에 대한 연구가 활발히 진행되고 있다. 기능적 이용성이 높은 수목 중에 하나인 전나무 (Abies holophylla Max.)는 풍부한 약리학적 효과를 가지고 있으며, 다양한 이차대사산물이 존재하는 상록침엽수종으로 알려져 있 다 (Lee and Hong, 2009). 예로부터, 민간요법에서는 전나무 속 추출물은 폐 질환, 감기, 소화불량, 류마티스, 복통 및 혈관 질환에 효과가 있는 것으로 알려져 왔고, 박테리아와 진균 등 에 대한 항미생물 활성, 항염 작용 등을 하는 것으로 보고되었 다 (Richardson et al., 1992; Yeşilada et al., 1995; Singh et al., 1998).
전나무는 관상, 조림, 건축, 가구의 재료로 이용되어 왔고, 한방에서의 사용은 뿌리와 잎으로부터 방향유를 채취하여 여 러 가지 약용으로 이용되는 것으로 보고되었다 (Lee et al., 2006). 생송진은 수증기로 증류하여 약으로 쓰이는 테레핀유 제조나 지혈제로 이용할 수 있음이 알려져 왔고, 고약을 만들 때 송진과 가지를 건류한 기름을 이용하여 급성 혈류에 문제 가 있을 때 사용하기도 하였다 (Lee et al., 2006).
일반적으로 정유 성분은 복합 천연화합물로서 식물이 자기 방어를 위한 2 차 대사산물로 알려져 왔고, 전나무의 정유 성 분은 뛰어난 항균 활성을 나타내어 화장품 산업에도 이용되고 있다 (Bakkali et al., 2008).
전나무의 정유 성분에 대한 항미생물 활성은 9 가지 박테리 아 계통의 항박테리아 활성이 보고되었다 (Jeong et al., 2007). 2 가지 전나무인 Abies holophylla와 Abies koreana의 정유 성분은 15 개 박테리아와 8 개 곰팡이에 대한 항미생물 활성 효과를 검증하였다 (Lee and Hong, 2009). 일반적인 정 유 성분의 주된 물질은 테르펜 화합물로서 식물계에 널리 분 포하고, 다양한 생리활성을 나타내며 항염증, 항산화, 항박테 리아 기작에 관여하는 물질로 알려져 있다 (Kim et al., 2016a).
본 연구에서는 1 차적으로 화장품 원료로 사용된 전나무 부 산물로부터 잔존하여 남아 있는 항산화 및 항미생물 활성의 정도를 알아보고자 실험하였다. 항산화 측정을 위해서는 DPPH 소거능 측정, ABTS 활성, total phenol 함량, total flavonoid 함량을 측정 하였으며, 항미생물 활성에 사용된 미생물 균주는 S. aureus, Bacillus subtilis, Salmonella typhimurium, Klebsiella pneumonia, 이상의 4 가지 균주를 가지고 활성 정도를 체크하 여 전나무 부산물을 이용한 산업화 재료 이용 가능성을 평가 하고자 실시하였다.
재료 및 방법
1. 식물 및 공시재료
국제홀리스틱힐링교육원에서 전나무 (A. holophylla Maxim) 로부터 화장품 원료로 사용할 오일 성분 추출 후 남은 전나무 부산물을 분양받아 실험에 이용하였다.
강원도 평창군 진부면의 전나무 잎을 채취하여 잔가지 제거 후 상온에서 1 주간 건조후 3㎏을 선별하여 100℃로 3 시간 동안 스팀추출기로 정유 추출한 후 남은 전나무 부산물을 실 험에 이용하였다. 항미생물 검정에 쓰인 공시균주는 생물자원 센터로부터 분양받았으며, Bacillus subtilis, (KCTC number 3728), S. aureus (KCTC number 1916), Salmonella typhimurium (KCTC number 1925), Klebsiella pneumoniae (KCTC number 2001), 이상의 4 가지 미생물을 실험재료에 사용하였다.
2. 식물 추출물 준비
화장품 오일 원료 추출후 남은 전나무 잎 부산물을 60℃의 건조기 (VS-1202D4N, Vision Scientific Co., Ltd., Daejeon, Korea)에서 건조시킨 후, 막자사발을 이용하여 분쇄하였다.
분쇄한 샘플은 물 온도별 (50℃와 100℃), 에탄올 (Daejung, Siheung, Korea) 농도별 (35%, 50%, 70%, 100%)로 나누어 추출하였다. 추출된 용액을 여과지 (MN020250, HYUNDAI Micro Co., Seoul, Korea)에 여과하여 농축하였고, 농축된 시 료를 50% 에탄올로 녹여 데이터 측정을 위해 시료를 준비하 였다.
3. DPPH를 이용한 항산화 활성 측정
DPPH를 이용한 항산화 활성값 측정은 Blois (1958)의 방법 을 변형한 Yoo 등 (2017)의 실험 방법에 따라 실험을 수행하 였다.
50 ppm농도로 준비한 100㎕ 샘플에 100㎕ 0.15 mM DPPH (2,2-diphenyl-1-picrylhydrazyl; Sigma-Aldrich Co., St. Louis, MO, USA)를 첨가하여, 암상태 상온에서 30 분 반응 시킨 후, UV-VIS spectrophotometer 기기 (Multiskan FC Microplate Photometer, Thermo Fisher Scientific Instruments Ltd., Waltham, MA, USA)를 이용하여 517㎚에서 흡광도 값 을 측정하였다. DPPH 라디컬 소거능은 10㎍/㎖ ascorbic acid (Amresco LLC., Solon, OH, USA)를 대조군으로 사용 하여 백분율 (%)로 계산하여 나타내었다.
4. ABTS를 이용한 항산화 활성 측정
ABTS를 이용한 항산화 활성값 측정은 Re 등 (1999)의 방 법을 변형한 Jeon 등 (2016)의 실험 방법에 따라 실험을 수 행하였다.
1 : 1 ABTS 혼합용액 [7.4 mM ABTS (2,2'-azino-bis-3- ethylbenzothiazoline-6-sulfonic acid; Sigma-Aldrich Co., St. Louis, MO, USA) + 2.6mM potassium persulfate (Daejung Chemicals and Metals Co., Ltd., Siheung, Korea)]을 암상태 로 실온에서 24 시간 반응시킨 후 UV-VIS spectrophotometer 를 이용하여 732㎚에서 흡광도 값이 0.70 (± 0.03)이 되는지 확인하였다. 준비된 용액을 phosphate saline (PBS, pH 7.4) 을 이용하여 희석하여 990㎕에 10㎕ 샘플을 첨가하여 10 분 반응시킨 뒤 740㎚로 UV-VIS spectrophotometer를 세팅 한 후 흡광도 값을 측정하였다. 대조군으로는 10㎍/㎖ ascorbic acid를 사용하였고, 50 ppm 농도인 각 샘플의 흡광 도 값을 백분율로 환산하여 나타내었다.
5. 총 페놀 함량
총 페놀 함량을 측정하기 위하여 수행된 실험은 Folin- Ciocalteu 가 고안한 방법을 약간 변형하여 응용하였다 (Taga et al., 1984).
100㎕ 샘플 (1,000 ppm)에 50㎕ Folin & Ciocalteu’s phenol 시약을 첨가하여 3 - 5 분 동안 반응시킨다. 20% Na2CO3 (Junsei Chemical Co., Ltd., Tokyo, Japan) 용액을 300㎕ 취하여 위의 반응 샘플에 첨가한 후, 15 분 동안 반응 시킨다. 마지막으로 1㎖의 distilled water를 넣고 2 분 동안 원심분리하여 96 well plate에 200㎕씩 분주한다. 725㎚로 세팅된 UV-VIS spectrophotometer 기기를 이용하여 흡광도 값을 조사하였다.
6. 총 플라보노이드 함량
총 플라보노이드 함량 측정을 위해서 Moreno 등 (2000)의 방법을 변형한 Kim 등 (2016b)의 실험 방법에 따라 수행하 였다.
E-tube에 100㎕의 10% aluminum nitrate (Junsei Chemical Co., Ltd., Tokyo, Japan)과 1M potassium acetate (Junsei Chemical Co., Ltd., Tokyo, Japan)를 혼합한 후, 500㎕ 샘플 (1,000 ppm)을 넣고 40 분간 반응시킨다. 반응 후 96 well plate에 150㎕씩 분주하고, 415㎚로 세팅된 UV-VIS spectrophotometer 기기를 이용하여 흡광도 값을 조사하였다.
7. 미생물 배양
전나무 부산물의 항미생물 활성을 측정하기 위해 그람양성 군에 속하는 Staphulococcus aureus (KCTC number 1916), Bacillus substilis (KCTC number 3728)와 그람 음성군인 Salomonella typhimurium (KCTC number 1925), Klebsiella pneumonia (KCTC number 2001)를 분양받아 실험에 이용하 였다.
4 가지 미생물은 LB (bacto-tryptone 10 g/ℓ, bacto-yeast 5 g/ℓ, NaCl 10 g/ℓ, pH 5.8)배지에 배양해서 50% glycerol 을 첨가하여 –80℃에 장기간 저장하였다. 실험을 위하여 장기 간 저장된 4 가지 미생물을 새로운 LB 액체 배지를 이용하여 37℃에서 배양한 것을 이용하였다.
8. 항미생물 활성 측정
미생물 최소 저해 농도 활성 (minimun inhibitory concentratio, MIC)은 샘플을 2 배씩 연속적으로 희석하여 체크하 였다. 이 MIC 설험의 모든 절차는 Kobayashi 등 (1993)이 사용한 방법을 고안하여 실험을 수행하였다.
멸균된 액체 배지를 이용하여 7.8 - 1,000㎍/㎖ 농도가 되도 록 맞추고, 최종 양은 샘플당 200㎕가 되도록 96 well micro plate에 준비하여 37℃에서 24 시간동안 150 rpm으로 배양하면서 체크하였다. 대조군으로는 tetracyclin (1,000 ppm) 을 사용하였고, 모든 MIC 활성은 3 반복으로 측정하여 결정 하였다.
9. Disc diffusion법을 이용한 항균 활성 분석
MIC법 분석에서 스크리닝한 미생물 중 항미생물 효과를 나 타낸 Staphylcoccus aureus 균을 대상으로 전나무 부산물의 disc diffusion법을 이용한 항균활성 정도를 분석하였다 (Seo et al., 2016).
제조한 LB agar 배지에 107- 108 CFU/㎖로 희석한 균 배 양액을 100㎕ 도말하였다. 균을 도말한 후, paper disc를 샘 플 (100㎎/㎖)에 흡수되도록 하여 균 도말한 배지에 접종하여 37℃에서 24 시간 동안 배양 정도를 관찰하였다. 생성된 clear zone을 측정하여 추출용매와 농도에 따른 항균 활성을 비교분 석하였다.
10. 통계처리
모든 데이터는 최소 3 반복 수행하여 평균 ± 표준편차로 나타냈었다. 통계처리는 종합 소프트웨어 IBM SPSS Statistics v24 (SPSS, Chicago, IL, USA)를 사용하여 Duncan’s Multiple Range Test (DMRT)로 유의성을 검증하였고, 통계적 유의성을 5% 수준에서 분석하였다.
결과 및 고찰
1. DPPH와 ABTS를 이용한 항산화능 분석
인체 내의 다양한 대사과정에서 생성되는 활성산소로 인한 산화적 스트레스로 인해 각종 만성 질병 등이 심화되고 있으 므로, 이런 문제를 해결할 수 있는 천연 항산화제를 개발하고 자 하는 연구가 활발히 이루어지고 있다 (Jeon et al., 2009).
대부분 천연 식물로부터 유래된 페놀 화합물로 인해 항산화 력이 있는 항산화제에 대한 연구와 역할 구명에 대한 연구가 많이 진행되어 왔다 (Lee et al., 2005). 현재까지 많이 쓰이고 있는 항산화제는 BHA와 BHT 로서 안정성은 뛰어나지만, 합 성성분 물질이기 때문에 천연 성분 유래의 항산화제 개발 성 과를 기대하고 있는 실정이다 (Huang et al., 1992). 현재 많 이 알려진 천연항산화제는 폴리페놀, 플라보노이드, 카로티노 이드, 아스코르브산, 토코페롤 등이 이에 속한다 (Huang et al., 1992).
화장품 원료로 쓰이는 정유 성분을 먼저 추출하고 남은 전 나무 (A. holophylla Maxim) 부산물에 잔존하는 항산화 활성 을 측정하기 위해 DPPH와 ABTS radical 소거능을 측정하여 백분율로 나타내었다 (Fig. 1, 2). DPPH와 ABTS radical 소 거능 활성 샘플은 50 ppm의 농도에서 항산화 활성을 보여주 는 것으로 나타났다.

Antioxidant effect using DPPH scavenging activity in Abies holophylla byproduct depending on temperature and concentrations of solvent. Means values from triplicate separated experiments are shown.*Means with difference letters are significantly different at p < 0.05 by Duncan’s Multiple Range Test (DMRT).

Antioxidant effect using ABTS scavenging activity in Abies holophylla byproduct depending on temperature and concentrations of solvent.Means values from triplicate separated experiments are shown. *Means with difference letters are significantly different at p < 0.05 by Duncan’s Multiple Range Test (DMRT).
DPPH radical 소거능 분석을 통해 50℃와 100℃ 열수 추 출물에서 각각 95.61%, 99.42%로 높은 항산화 수치가 검정되 었다. 에탄올 농도가 높아질수록 추출물에 대한 DPPH 전자소 거능이 낮아지는 것으로 나타났다. DPPH radical 소거능 수치 의 결과에서 보면, 50℃와 100℃라는 추출 온도에 있어서는 항 산화활성 차이가 나타나지 않았으며, 에탄올은 50% 이상 농도 로 추출한 결과 항산화능이 오히려 낮아지는 것으로 나타났다.
일반적으로 높은 항산화능을 나타내기 위해 쓰이는 에탄올 을 용매로 이용하지 않아도 열수추출을 하면 높은 항산화활성 을 나타나는 것으로 조사되었다 (Fig. 1).
ABTS radical 소거능을 측정한 결과, 35% 에탄올로 추출했 을 때 61.27%로 가장 낮은 항산화능을 갖는 것으로 나타났다. ABTS radical 소거능 측정의 경우는 용매 농도별, 물 온도별 항 산화능의 차이가 크게 나타나지 않는 것을 확인할 수 있었다. 하지만, 전체적인 항산화 수치 패턴은 DPPH radical 소거능 수치 양상과 유사한 경향을 보여주는 것으로 나타났다 (Fig. 2).
전나무를 이용한 항균과 항염에 관한 연구는 많이 시행되어 왔지만, 항산화에 대한 연구는 극히 제한적이다. 소나무과 4 종을 이용한 항산화 활성 분석 보고에서 나무껍질, 잎 등 부 위별로 나누어 에탄올 추출물로 DPPH radical 소거능 분석법 을 이용하여 측정한 결과, 껍질 부분에서는 4 종의 수종 모두 ascorbic acid와 유사한 항산화 활성을 나타냈으며, 잎부분도 100㎍/㎖에서 대조구로 쓰인 표준물질보다 항산화능이 높은 것으로 나타났다 (Ahn and Bae, 2005).
소나무의 솔방울의 ethyl acetate 분획물의 DPPH와 ABTS radical 소거능을 측정한 결과, 추출물 농도가 증가될수록 DPPH와 ABTS radical 소거능 활성이 증가하는 것으로 보고 되었다 (Jang et al., 2016). 소나무과에 속하는 전나무의 잎 부위를 이용한 항산화 연구에서, 조추출물에서는 항산화능이 나타나지 않았고, 잎 추출물의 각 분획물에서만 항산화능이 있 는 것으로 조사되었다 (Lee et al., 2006).
이와는 달리, 본 연구에서는 전나무 부산물 조추출물을 가 지고 실험한 결과 항산화능이 있는 것으로 조사되었다. 이미 화장품에 쓰이는 많은 정유성분을 추출한 상태이기 때문에 활 성이 없을 것으로 생각되었지만, 실험해 본 결과 전나무 부산 물에서도 항산화능이 조사된 것으로 보아, 전나무 부산물을 이 용하여 화장수나 농업적 이용 제품 등의 2 차 산업 제품을 개발할 수 있을 것으로 사료된다.
2. 총 페놀성 화합물과 총 플라보노이드 함량 비교 분석
총 페놀 함량이 가장 높은 것으로 측정된 샘플은 50% 에 탄올 추출물로서 389.84㎎·GAE/g로 나타났다. 가장 낮은 총 페놀 함량 수치는 2.03㎎·GAE/g으로서, 50℃ 열수추출물 조 건인 것으로 조사되었다. 열수추출물 보다는 에탄올 추출물에 서 전반적인 총 페놀 함량은 높은 것으로 나타났다 (Fig. 3). 플라보노이드 함량은 열수추출물 샘플에서는 0.01㎎·QE/g 이 하의 수치로 나타나, 50%와 100% 에탄올 추출물과 비교하면 15 배 정도 (0.15㎎·QE/g)추출물에 총 플라보노이드 함량이 많은 것으로 조사되었다.

Total phenol content in Abies holophylla byproduct depending on temperature and concentrations of solvent.Means values from triplicate separated experiments are shown. *Means with difference letters are significantly different at p < 0.05 by Duncan's Multiple Range Test (DMRT).
소나무의 솔방울 추출물의 총 페놀성 화합물 함량은 27.3 ± 0.3㎎/g 으로 보고되었다 (Jang et al., 2016). P. densiflora 톱밥으로부터 추출한 정유 성분에는 약 5.7%의 페놀성 화합 물이 조사되었고, 수피에서는 5.1%의 페놀성 화합물이 존재하 고 있는 것으로 밝혀졌다 (Ku et al., 2007; Patra et al., 2015). 소나무 껍질 추출물 (PineXol®)의 총 페놀성 화합물과 총 플라보노이드 함량은 각각 717.40 ± 6.86 GAE·㎎/g, 54.44 ± 0.01 QE·㎎/g으로 측정되었다 (Lee et al., 2013).
본 연구에서 측정된 총 페놀성 화합물 함량 389.84㎎·GAE/ g 수치는 전나무 정유 성분을 1 차 추출 후 남은 부산물을 이 용한 추출물로부터 확인된 수치로서, 전나무를 화장품 원료로 제공하는 정유 성분 1 차 추출 후에도 상당한 페놀 함량이 남아 있는 것으로 확인되어 부산물을 이용한 2 차 화장수 제 품화도 가능할 것으로 보인다.
3. 박테리아에 대한 항미생물 활성 분석
4 가지 박테리아 (S. aureus, B. subtilis, S. typhimurium, K. pneumonia)에 대한 전나무 부산물의 항박테리아 활성을 측 정하기 위해 먼저 MIC방법으로 조사하였다. 4 가지 박테리아 중 S. aureus만이 각 추출 샘플마다 항미생물 활성이 있는 것 으로 밝혀졌다. Fig. 4

Total flavonoid content in Abies holophylla byproduct depending on temperature and concentrations of solvent.Means values from triplicate separated experiments are shown. *Means with difference letters are significantly different at p < 0.05 by Duncan's Multiple Range Test (DMRT).
각 농도별 에탄올 추출물에서는 S. aureus에 대해 8 ㎍/㎖ 이하의 박테리아 저해 활성이 나타났으며, 각 온도별 열수추 출물에 있어서는 125㎍/㎖ 이하의 박테리아 저해능이 있는 것으로 확인되었다. 전나무 부산물 추출물은 나머지 3 가지 박 테리아에 대해서는 항미생물 활성이 없는 것으로 조사되었다 (Table 1).

Minimal inhibitory concentration (MIC) from the ethanol and water extracts of Abies holophylla byproducts.
전나무 부산물 추출물이 항미생물 활성을 보여주는 S. aureus 균을 사용하여 paper disc diffusion법을 이용한 항미생 물 저해능을 더 심층적으로 분석하였다. tetracycline을 대조군 으로 하여 조사한 결과, 에탄올 농도별 (35%, 50%, 70%, 100%) 미생물 고체 배지에서의 paper disc 주변에 나타나는 clear zone을 육안으로 확인할 수 있었다 (Fig. 5).
Antimicrobial activity against Staphylcoccus aureus.T; tetracycline (positive control), –; 50% EtOH (negative control), A; 35% EtOH extract of Abies holophylla byproduct, B; 50% EtOH extract of Abies holophylla byproduct, C; 70% EtOH extract of Abies holophylla byproduct, D; 100% EtOH extract of Abies holophylla byproduct, E; 50℃ extract of Abies holophylla byproduct, F; 100℃ extract of Abies holophylla byproduct.
Paper disc 주변의 clear zone을 육안으로 확인한 결과, 온도 별 열수추출물을 제외한 나머지 조건 추출물 처리에서는 clear zone을 형성하는 것으로 보여져 전나무 부산물의 각 농도별 에 탄올 추출물에서 S. aureus에 대한 높은 항박테리아 활성을 나 타내는 것으로 조사되었다. 육안으로 확인된 clear zone을 측정 한 결과, 35%와 50% 에탄올추출물은 10 ㎜ 미만의 clear zone 이 측정되었으며, 50% 와 100% 에탄올추출물을 이용한 실험군 에서 10㎜이상의 clear zone이 형성되어 S. aureus에 대한 높은 항미생물 활성을 보여주는 것으로 재차 확인되었다 (Table 2).
전나무의 에센셜 오일 추출물을 retention fraction (RF)별로 나누어 실험한 결과, fraction D (RF value: 0.3)에서 K. pneumoniae와 S. pyogenes에 대한 항박테리아 활성이 crude oil을 이용한 실험구보다 더 높은 것으로 보고되었다 (Lee et al., 2014). 항진균 활성에 대한 연구는 2 가지 전나무 (A. holophylla와 A. koreana)종의 에센셜 오일을 이용하여Candida glabrata에 대한 항균 활성이 높은 것으로 보고되었다 (Lee and Hong, 2009). 전나무의 에센셜 오일 성분에 대한 항미생 물 활성은 몇가지 보고된 사례의 연구가 되어 있으나, 전나무 부산물을 이용한 항균 활성 연구는 본 연구에서 처음으로 다 루는 것으로 전나무 부산물에 대한 항박테리아 활성 이외에도 항진균에 대한 활성도 연구할 가치가 있을 것으로 사료된다.
본 연구에서 화장품 원료로 1 차 정유 성분을 추출한 전나 무 부산물을 이용한 다양한 항산화 활성 정도와 항박테리아 활성을 검정하였다. 이상의 결과들로부터 DPPH radical 소거 능, ABTS radical 소거능, 총 페놀성 화합물 함량, 총 플라보 노이드 함량의 수치 확인 결과, 부산물임에도 불구하고 높은 항산화 활성이 있는 것으로 나타났으며, S. aureus 박테리아에 대한 항박테리아 활성도 지니고 있는 것으로 확인되었다. 따 라서 전나무 부산물은 기능성 원료로서 2 차 산업화 제품의 응용 가능성이 있을 것으로 기대된다.
감사의 글
본 연구는 2017년도 강원대학교 대학회계 연구비 지원과 한 방바이오 연구소 지원에 의해 이루어진 결과로 이에 감사드립 니다.
References
- Ahn, J.Y., Bae, J.H., (2005), Evaluation of biological activities on the extractives of Pinaceae., Journal of the Society of Cosmetic Scientists of Korea, 31, p121-125.
-
Bakkali, F., Averbeck, S., Averbeck, D., Idaomar, M., (2008), Biological effects of essential oils-a review., Food Chem. Toxicol, 46, p446-475.
[https://doi.org/10.1016/j.fct.2007.09.106]

-
Blois, M.S., (1958), Antioxidant determinations by the use of a stable free radical., Nature, 181, p1199-1200.
[https://doi.org/10.1038/1811199a0]

-
Bolormaa, Z., Kim, M.K., Seo, G.S., Lee, Y.W., Lee, J.S., (2011), Screening and physiological functionality of Hypsizygus marmoreus(white cultivar) fruiting body., Korean Journal of Mycology, 39, p185-188.
[https://doi.org/10.4489/kjm.2010.39.3.185]

- Farjon, A., Rushforth, K.D., (1989), A classification of Abies Miller(Pinaceae)., Notes R. Bot. Gard. Edinb, 46, p59-79.
-
Huang, M.T., Ho, C.T., Wang, Z.Y., Ferraro, T., Finnegan-Olive, T., Lou, Y.R., Mitchell, J.M., Laskin, J.D., Newmark, H., (1992), Inhibitory effect of topical application of a green tea polyphenol fraction on tumor initiation and promotion on mouse skin., Carcinogenesis, 13, p947-954.
[https://doi.org/10.1093/carcin/13.6.947]

-
Jang, T.W., Nam, S.H., Park, J.H., (2016), Antioxidant activity and inhibitory effect on oxidative DNA damage of ethyl acetate fractions extracted from cone of red pine(Pinus densiflora)., Korean Journal of Plant Resources, 29, p163-170.
[https://doi.org/10.7732/kjpr.2016.29.2.163]

-
Jeon, G.I., Yoon, M.Y., Park, H.R., Lee, S.C., Park, E., (2009), Neuroprotective activity of Viola mandshurica extracts on hydrogen peroxide-induced DNA damage and cell death in PC12 cells., Ann. N. Y. Acad. Sci, 1171, p576-582.
[https://doi.org/10.1111/j.1749-6632.2009.04889.x]

-
Jeon, M.R., Yoo, J.H., Kim, C.H., Choi, J.H., Kang, B.J., Seong, E.S., Yu, C.Y., (2016), Selection of superior sorghum accession by assessing agronomic characters and biological activity., Korean Journal of Medicinal Crop Science, 24, p386-392.
[https://doi.org/10.7783/kjmcs.2016.24.5.386]

-
Jeong, S.I., Lim, J.P., Jeon, H., (2007), Chemical composition and antibacterial activities of the essential oil from Abies koreana., Phytother. Res, 21, p1246-1250.
[https://doi.org/10.1002/ptr.2229]

-
Kim, C.J., Seong, E.S., Yoo, J.H., Lee, J.G., Kim, N.J., Choi, S.K., Lim, J.D., Yu, C.Y., (2016), Biological activity of Panax ginseng C. A. Meyer culture roots fermented with microorganisms., Korean Journal of Medicinal Crop Science, a 24, p191-197.
[https://doi.org/10.7783/kjmcs.2016.24.3.191]

-
Kim, S.H., Lee, S.Y., Cho, S.M., Hong, C.Y., Park, M.J., Choi, I.G., (2016), Evaluation on anti-fungal activity and synergy effects of essential oil and their constituents from Abies holophylla., Journal of Korean Wood Science and Technology, b 44, p113-123.
[https://doi.org/10.5658/wood.2016.44.1.113]

-
Kobayashi, A., Koguchi, Y., Takahashi, S., Kanzaki, H., Kawazu, K., (1993), ST-1, a novel radical scavenger from fungus F-124., Biosci. Biotechnol. Biochem, 57, p1034-1046.
[https://doi.org/10.1271/bbb.57.1034]

-
Ku, C.S., Jang, J.P., Mun, S.P., (2007), Exploitation of polyphenolrich pine barks for potent antioxidant activity., J. Wood Sci, 53, p524-528.
[https://doi.org/10.1007/s10086-007-0896-6]

-
Lee, J.H., Hong, S.K., (2009), Comparative analysis of chemical compositions and antimicrobial activities of essential oils from Abies holophylla and Abies koreana., J. Microbiol. Biotechnol, 19, p372-377.
[https://doi.org/10.4014/jmb.0811.630]

- Lee, S.K., Choi, D.H., Bae, Y.S., (2006), A study on the extractives of domestic major softwood needles(I)., Mokchae Konghak, 34, p73-83.
- Lee, S.Y., Hwang, E.J., Kim, G.H., Choi, Y.B., Lim, C.Y., Kim, S.M., Antifungal and antioxidant activities of extracts from leaves and flowers of Camellia japonica L., Korean Journal of Medicinal Crop Science, (2005), 13, p93-100.
-
Lee, S.Y., Kim, S.H., Park, M.J., Lee, S.S., Choi, I.G., (2014), Antibacterial activity of essential oil from Abies holophylla against respiratory tract bacteria., Journal of Korean Wood Science and Technology, 42, p533-542.
[https://doi.org/10.5658/wood.2014.42.5.533]

- Lee, T.B., (1987), Dendrology, Hyangmoon Publishing Company, Seoul, Korea, p331.
- Lee, Y.J., Han, O.T., Choi, H.S., Lee, B.Y., Chung, H.Y., Lee, O.H., (2013), Antioxidant and anti-adipogenic effects of PineXolA(r)., Korean J. Food Sci. Technol, 45, p97-103.
-
Moreno, M.I.N., Isla, M.I., Sampietro, A.R., Vattuone, M.A., (2000), Comparison of the free radical-scavenging activity of propolis from several regions of Argentina., J. Ethnopharmacol, 71, p109-114.
[https://doi.org/10.1016/s0378-8741(99)00189-0]

- National Research Council, (1991), Managing global genetic resources, National Research Council, Washington, DC, USA, p228.
-
Patra, J.K., Kim, S.H., Hwang, H., Choi, J.W., Baek, K.H., (2015), Volatile compounds and antioxidant capacity of the bio-oil obtained by pyrolysis of Japanese red pine(Pinus densiflora siebold and zucc)., Molecules, 20, p3986-4006.
[https://doi.org/10.3390/molecules20033986]

-
Re, R., Pellegrini, N., Proteggente, A., Pannala, A., Yang, M., Evans, C.R., (1999), Antioxidant activity applying an improved ABTS radical cation decolorization assay., Free Radic. Biol. Med, 26, p1231-1237.
[https://doi.org/10.1016/s0891-5849(98)00315-3]

-
Richardson, M.D., Peterson, J.R., Clark, A.M., (1992), Bioactivity screenings of plants selected on the basis of folkloric use or presence of lignans in a family., Phytother. Res, 6, p274-278.
[https://doi.org/10.1002/ptr.2650060511]

-
Seo, G.E., Kim, S.M., Pyo, B.S., Yang, S.A., (2016), Antioxidant activity and antimicrobial effect for foodborne pathogens from extract and fractions of Sanguisorba officinalis L., Korean Journal of Medicinal Crop Science, 24, p303-308.
[https://doi.org/10.7783/kjmcs.2016.24.4.303]

- Singh, R., Nath, G., Goel, R., Bhattacharya, S., (1998), Pharmacological actions of pharmacological actions of Abies pindrow royle leaf., Indian J. Exp. Biol, 36, p187-191.
-
Taga, M.S., Miller, E.E., Pratt, D.E., (1984), Chia seeds as a source of natural lipid antioxidants., J. Am. Oil Chem. Soc, 61, p928-931.
[https://doi.org/10.1007/bf02542169]

- Ye Yilada, E., Honda, G., Sezik, E., Tabata, M., Fujita, T., Tanaka, T., Takeda, Y., Takaishi, Y., (1995), Traditional medicine in Turkey. V. folk medicine in the inner taurus mountains., J. Ethnopharmacol, 46, p133-152.
-
Yoo, J.H., Choi, J.H., Kang, B.J., Jeon, M.R., Lee, C.O., Kim, C.H., Seong, E.S., Heo, K., Yu, C.Y., Choi, S.K., (2017), Antioxidant and tyrosinase inhibition activity promoting effects of perilla by the light emitting plasma., Korean Journal of Medicinal Crop Science, 25, p37-44.
[https://doi.org/10.7783/kjmcs.2017.25.1.37]
